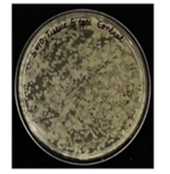
Human infected tissue control
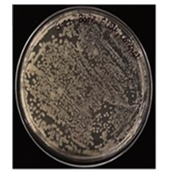
Human infected bone control

8537 Greenbriar St. || Wichita KS || 67226 || 316-796 4110
FOOT INFECTIONS ARE A SERIOUS PROBLEM FOR DIABETICS. FOOT ULCERS (DFU) START SMALL BUT WILL QUICKLY SPREAD BECAUSE (1) WOUND CARE AND (2) ANTIBIOTICS FAIL TO PENETRATE AND CONTROL THE MULTIPLYING BACTERIA.
FACT: 80% OF ALL FOOT ULCERS BECOME AN INFECTION IN DEEP TISSUE AND BONE. TO STOP THE SPREAD, SURGURY OR AMPUTATION IS NEEDED. IN THE USA THERE ARE 160,000 AMPUTATIONS YEARLY. COST TO THE HEALTHCARE SYSTEM IS ENORMOUS

ANTIBIOTICS
REALITY: ANTIBIOTICS STRUGGLE TO CONTROL INFECTIONS BECAUSE:
(1) PERIPHERAL VASCULAR DISEASE.
(2) ANTIMICROBIAL RESISTANCE.
(3) BACTERIAL MUTATIONS.
A. The Search for a Better Treatment: Antibiotic Treatment is limited because of peripheral vascular disease and bacterial mutations. Without an alternative treatment, gangrene and sepsis become life-threatening.
B. Unstoppable Bacterial Mutation: As the numbers of bacteria increase in the infection, there is the inevitable mutation of that bacteria, amplified by the use of antibiotics. Once a mutant resistant is present, it dominates the bacterial population. It uses the excess glucose to accelerate the infection into deeper foot tissue and leg bone.* Antibiotics become ineffective.

C. Understanding Bacteria’s Vulnerability: It is common knowledge that bacteria absorb iron. Iron is an essential nutrient used by bacteria for cell growth and metabolism. Bacteria biosynthesizes the iron into intracellular nanoparticles. Iron nanoparticles are paramagnetic. Coincidentally, Magnetic Hyperthermia will easily over-heat those naturally occurring nanoparticles. Bacteria cell death follows.
D. Conclusion: Magnetic Hyperthermia (AMF) is a Quasi-Drug Treatment that uses bacteria’s own iron nanoparticles against itself. (1) AMF Heating causes the bacteria cell walls to rupture. (2) There is a rise in oxygen species (ROS) inside the bacteria cell structure. (3) Both phenomena result in significant bacteria cell death. (4) The surrounding healthy tissue remains unharmed. (5) The macrophages consume the dead bacteria cells. (6) The immune system assists recovery. *UNC School of Medicine / Nanoscale 2022 /*** JAMAL Int. Medicine
Common Sense Technology to Control Infections
Magnetic Hyperthermia: It exploits the naturally occurring biosynthesis of iron that bacteria absorb and use for its own metabolism. Magnetic Heating (AMF) of the bacteria cell’s iron nanoparticles causes self-heating and then cell death. Dynamically, (1) AMF can penetrate the bacterial biofilm. (2) AMF bypasses the peripheral vascular disease. (3) AMF opens a pathway for antibiotics to more easily reach the infection. (4) AMF ignores bacterial mutations, easily killing the infected bacteria.

1. Computer Control: The computer controls heating at the FDA limit.

2. Hand Unit is light weight and can apply heating to a Foot or Leg.
MAGNETIC FIELD PROJECTED

INTO FOOT ULCER*

*Early AMF Treatment of this foot ulcer could have reversed the infection. Controls: Temperature Measurement + Magnetic Field.
E-Coli Infection

E-Coli Infection

Tissue samples taken from live patients whose infections spread despite antibiotic treatment. (C) E. Coli infected muscle sample. (D) E.Coli infected bone sample. Both treatments were exposed to magnetic hyperthermia heating (AMF) for 5-15 minutes. Longer exposure results in higher death rate for the bacteria. Scanning electron microscope images revealed the destruction of the bacterial cell wall. AMF treatment also resulted in excess reactive oxygen species formation, which might contribute to bacteria cell death. As required by the FDA: A lengthy safety study of 25 female rats showed an overall lack of significant edematous response to AMF. (Journal of the Royal Society of Chemistry 2022: NanoScale,14. 1713...)
RF Magnetic Heating: Study of Impact on Living Tissue
(Dec. 2022 – Dec. 2024) / Institute of NanoScience and Technology)
Exploratory Study to evaluate the efficacy of alternate magnetic field (AMF) to reduce bacterial load in human subjects with bacterial infections in the limbs. Study type: Academic clinical trial. PI’s: Dr. Sanjay P.I.: Bhadada (Dept. Endocrinology), Dr. Sameer Aggarwal (Depa. Orthopedics) and Dr. Vikas Gautam (Medical Microbiology Dept), PGIMER, Chandigarh Co-PI: Dr. Deepa Ghosh, INST, Mohali, INDIA

Sanjay P.I.: Bhadada (Dept. Endocrinology), Dr. Sameer Aggarwal (Depa. Orthopedics) and Dr. Vikas Gautam (Medical Microbiology Dept), PGIMER, Chandigarh Co-PI: Dr. Deepa Ghosh, INST, Mohali, INDIA
To confirm the safety of continuous/pulsed AMF, we exposed cohorts of female SD rats to AMF of 225 kHz, 325 Oe / 5.3 10(9)* and 375 kHz, 320 Oe / 9.3 10(9)*, respectively. A total of 25 female rats, inclusive of one acting as the control, underwent diverse treatment regimens employing AMF. The Pulsed treatment involved subjecting 4 rats AMF treatment in precise intervals of 5 minutes of treatment, 5 minutes of rest, followed by an additional 5 minutes of treatment. Subsequently, two rats were sacrificed on the same day, while the remaining two underwent sacrifice the following day. Similarly, 4 rats were similarly analyzed after continuous treatment of 10 minutes. Furthermore, two separate cohorts, each comprising four rats, underwent repeated continuous treatments at 7-day intervals, culminating in their sacrifice after an aggregate period of 21 days. Analysis of the exposed skin to AMF, showed no significant changes on visualization after treatment (Fig 6). The absence of observable signs of paw swelling or edema across the experimental conditions implied an overall lack of significant edematous responses to AMF (Fig.7). This was confirmed with the consistent measurements of paw size that suggested an absence of inflammation in the paws on exposure to AMF (Fig. 8).
Histological examinations of skin and muscle tissues from rats exposed to AMF showcased no notable changes in comparison to control groups. Microscopic analyses revealed (1) intact tissue architecture, (2) the absence of necrotic foci, (3) inflammatory responses, or (4) other discernible alterations in both skin (Fig. 9) and muscle sections (Fig. 10). These findings suggest a lack of substantial tissue damage or inflammatory reactions elicited by the applied AMF.
*Proposal of New Safety Limits for In Vivo Experiments of Magnetic Hyperthermia Antitumor Therapy: Cancers 2022, 14(13), 3084; https://doi.org/10.3390/cancers14133084

Dr. Deepa Ghosh of The Institute of Nano Science and Technology / (Mohali, India). Aug 7, 2022
Nanoscale DOI: 10.1039/d1nr07435k (pp 1713-1722)
Laboratory Results: The extensive and indiscriminate use of antibiotics in the ongoing COVID-19 pandemic has significantly fueled the growth of Multiple Drug Resistant (MDR) bacteria. With the dwindling pipeline of new and effective antibiotics, we might soon end up in a post-antibiotic era, in which even common bacterial infections would be a challenge to control. Several approaches are being pursued to combat this growing threat. Hyperthermia, the process of heating diseased tissue to an elevated temperature for a limited time is considered a promising treatment option for cancer and other diseases. The Magnetic-Hyperthermia mediated anti-cancer treatment is approved for use in the USA and EU. Bacteria, similarly, are reported to be susceptible to hyperthermia. Magnetic nanoparticles-mediated hyperthermia has several advantages as compared to other conventional hyperthermia approaches. Upon exposure to the MNP to an alternating magnetic field (AMF) of high frequency, heat is generated. Presence of MNP inside the cells can cause cell death through over-heating.
MNP’s are generally prepared using a synthetic approach and modified further to target the bacteria in the host. Such approaches, nevertheless face several hurdles including: (1) The influence of size and shape of the MNP’s on magnetic heating: (2) The selective targeting of infectious bacteria (present inside/outside the cells) in the host. (3) Overcoming its toxicity on account of high concentration. (4) Solubility issues. Therefore, to achieve effective MNP-mediated anti-bacterial strategy, it would be ideal for the bacteria to form by itself the intracellular MNP. Invading virulent bacteria require iron and zinc for its survival. When over-treated with iron and zinc supplements, we observed that both Gram-Positive and Gram-Negative bacteria form and store intracellular MNP.
Upon exposure of the bacteria for 20-30 minutes with AMF (360 kHz / 400 Oe), we observed a hyperthermia response with 3-5 log reduction in live bacterial load. The hyperthermia anti-bacterial treatment was confirmed using multiple patient specimens (with different pathogens).
“This validates the clear potential of the drug-free strategy to address the infection.” (Dr. Deepa Ghosh)
Recent CDC Infection Data indicates a “Surge in Infections” since 2019 and COVID. Over-Prescription of antibiotics is much of the cause. WHO reports that bacteria are mutating constantly. Infections will cause more deaths than cancer by 2030. (WHO)

Summary: (1) Many infections fail to be controlled in the beginning because of the well known Antibiotic Limitations. (2) Widespread Over-Use of Antibiotics has resulted in predictable Antimicrobial / Anti-Bacterial Resistance. (3) Antibiotics is infiltrating through waste water into the land and sea, causing havoc to the Ecosystem and Food Supply. (4) True Innovation in Medical Technology is hampered by the Institutional Bias of both the Medical Community and the Pharmaceutical Industry that, together, prefer the status quo: Drug Treatment and Surgery.
Magnetic Hyperthermia (AMF) Enhances Antibiotic Treatment
1. 80% of all foot and lower limb infections start with Foot Ulcers. (DFU)
AMF kills foot ulcer bacteria easily, stopping the infection.
2. Antibiotics is blocked by peripheral vascular disease.
AMF ignores blood circulation problems.
3. Hospitals report 30-50% of infections are drug resistant.
AMF treatment attacks the infection without drugs.
4. Antibiotics cause drug-resistant mutations.
AMF causes no bacteria mutations.
5. Each Bacteria Strain may need a specific Antibiotic.
AMF ignores different bacteria strains.
6. Wound Healing is blocked by the bacterial biofilm.
AMF ignores and penetrates the biofilm easily.
7. Patients on Antibiotics are at risk from side effects. (CDC)
AMF causes no side effects on the patient’s health.
8. WHO reports 8.5% of all cancer deaths are by infections. AMF is a safe infection treatment for cancer patients..
9. Antibiotics cannot penetrate the bone.
AMF easily penetrates the bone to kill the infection. It saves the patient from a very likely leg amputation.
10. Antibiotic Over-Use can threaten the ecosystem.
AMF is Biogenic and does not alter nature or the ecosystem
11. New antibiotics can take years and $ millions to develop.
AMF costs pennies for each treatment.
POWER SUPPLY REAR VIEW

Rear of the Cabinet: Power Disconnect Switch, Circuit Breaker, Water Inlet and Outlet, Water Pressure Gauge, Control Cable to Heat Station or Portable Unit.
Interface Connections:
1. +24 VDC Auxiliary Supply
2. Fiber Optic Sensors (1-2)
3. Magnetic Field Sensor
4. USB Port Connects to Touch Screen and Customer Computer
5. Type J Thermocouple Socket
6. External Control Cable Socket
7. RS-232 / RS- 485 Ports.
8. Aux.

MSI AUTOMATION, INC.
8537 GREENBRIAR ST., WICHITA, KANSAS USA 67226
316-796 4110 WEB SITE: WWW.MSIAUTOMATION.COM-
E.Mail: DAVE@MSIAUTOMATION.COM
International Representatives:
Hong Kong/Shanghai: www.worldwide-china.com / Romania: www.pro-tehnic.ro
India: www.alliedscientific.net /Singapore: www.dmxproducts.com